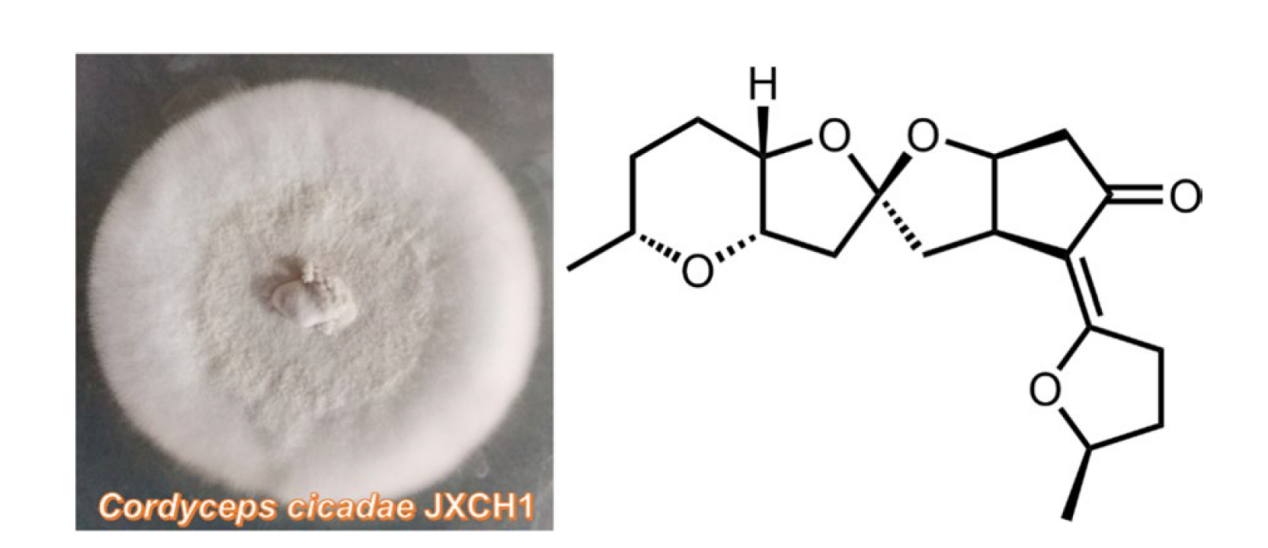

The Discovery of Anticancer Drugs from Natural Products
Published in Cancer, Chemistry, and Cell & Molecular Biology
Natural products continue to serve as an invaluable source of structural diversity for anticancer drug discovery. This special feature, presenting recent studies from Natural Products and Bioprospecting, showcases the latest advances in the field, systematically highlighting this potential.
1. Targeting Hsp70 triggers ferroptosis: a novel anti-cancer mechanism of a marine natural product in prostate cancer
Highlight: This study identifies Nidurufin (Nid) as a novel HSP70-targeting compound that induces ferroptosis in AR-positive prostate cancer cells. Nid directly binds HSP70, disrupting its chaperone function and leading to AR protein destabilization. This subsequently downregulates the AR-target gene MBOAT2, a key ferroptosis suppressor, thereby triggering ferroptotic cell death. The findings validate the HSP70-AR-MBOAT2 axis and position HSP70 as a promising therapeutic target to overcome AR dependency in prostate cancer.
Keywords: Prostate cancer, Heat shock protein 70, Androgen receptor, Membrane-associated O-acyltransferase domain protein 2, Ferroptosis, Marine natural product
Full Article: https://link.springer.com/article/10.1007/s13659-025-00586-9

2. The ethyl acetate extract from Trichoderma viridefermentation acts by downregulating the leukocyte transendothelial migration signaling pathway to induce ferroptosis in triple-negative breast cancer cells
Highlight: Trichoderma viride ethyl acetate extract (TVEAE) exhibits significant anti-Triple-Negative Breast Cancer (TNBC) efficacy validated in both in vitro and in vivo models. Mechanistically, it triggers ferroptosis—a regulated cell death pathway—by selectively modulating the leukocyte transendothelial migration (TEM) signaling axis. Integrated multi-omics analysis identified IL-6, TNF-α, and HSP90AA1 as core therapeutic targets. Chemical profiling via GNPS revealed six anti-TNBC metabolites, including Gliotoxin and erucamide.
Keywords: Trichoderma viride, Triple-negative breast cancer, Leukocyte transendothelial migration, Ferroptosis
Full Article: https://link.springer.com/article/10.1007/s13659-025-00569-w

3. Senkyunolide H reverses depression induced breast cancer progression by regulating CXCR2
Highlight: This study identifies IL-8 as a key mediator in depression-associated breast cancer progression. Through transcriptomic analysis and Mendelian randomization, IL-8 was found to promote tumor growth via its receptor CXCR2. The compound senkyunolide H was shown to inhibit this pathway by regulating CXCR2, effectively counteracting the pro-tumor effects of depression in both in vitro and in vivo models.
Keywords: Breast cancer, Depression, IL-8, CXCR2, Senkyunolide H
Full Article: https://link.springer.com/article/10.1007/s13659-025-00543-6

4. Dual inhibition of FAS and HAS2/3 by 4- MU in Realgar-Coptis chinensis unveils a metabolic checkpoint for liver cancer therapy
Highlight: This study identifies 4-Methylumbelliferone (4-MU) as the key active compound in the Realgar-Coptis chinensis drug pair against hepatocellular carcinoma. 4-MU inhibits tumor growth by targeting fatty acid synthase (FAS) to induce apoptosis and suppressing HAS2/3 to disrupt the tumor microenvironment, as validated by in vivo experiments.
Keywords: 4-MU, Liver cancer, Cancer, Lipid metabolism, MST
Full Article: https://link.springer.com/article/10.1007/s13659-025-00540-9

5. Synthesis and biological activity study of tanshinone I-pyridinium salt derivatives
Highlight: Twenty novel tanshinone I-pyridinium salt derivatives were synthesized to overcome the weak potency and poor drug-like properties of natural tanshinone I. Compound a4 exhibited the strongest cytotoxicity against multiple cancer cell lines (IC50: 1.40–1.63 μM). Mechanistically, a4 acts as a PI3Kα inhibitor, suppressing the PI3K/Akt/mTOR pathway and downregulating PD-L1 expression, highlighting its potential as an anticancer agent.
Keywords: Tanshinone I, Pyridinium salts, Structural modification, Antitumor activity, Structure–activity relationship
Full Article: https://link.springer.com/article/10.1007/s13659-025-00534-7

6. Natural anticancer agents: prospection of medicinal and aromatic plants in modern chemoprevention and chemotherapy
Highlight: This in-depth review consolidates significant findings on natural products with anticancer potential from medicinal and aromatic plants. It not only covers successful natural product-derived drugs used in clinical therapy, such as Docetaxel, Etoposide, and Topotecan, but also highlights promising molecules like Hinokitiol, Hesperetin, and Epigallocatechin gallate, which have shown efficacy against multiple cancer types. The review underscores the imperative for continued bioprospecting efforts.
Keywords: Medicinal and aromatic plants, Chemoprevention, Chemotherapy, Vegetable extracts, Essential oils, Natural volatiles, Cancer cell lines
Full Article: https://link.springer.com/article/10.1007/s13659-025-00511-0

7. Metabolism characterization and toxicity of N-hydap, a marine candidate drug for lung cancer therapy by LC-MS method
Highlight: Focusing on the marine natural product N-hydap, which shows promise against Small Cell Lung Cancer (SCLC), this study systematically elucidates its in vitro metabolic pathways, pharmacokinetic properties, and the potential to create drug-drug interactions (DDIs). A key finding is that N-hydap exhibits a high distribution in the lungs, which accounts for its efficacy against SCLC, and it has a favorable oral bioavailability. These findings provide crucial pharmaceutical data supporting its further development towards clinical studies.
Keywords: N-Hydap, Metabolism, Pharmacokinetics, DMEs, Toxicity, DDIs
Full Article: https://link.springer.com/article/10.1007/s13659-024-00455-x

8. Narciclasine, a novel topoisomerase I inhibitor, exhibited potent anti-cancer activity against cancer cells
Highlight: This study is the first to identify the Amaryllidaceae alkaloid Narciclasine (NCS) as a novel inhibitor of topoisomerase I (topo I). It acts by inhibiting topo I activity (as a suppressor, not a poison), potently inhibits the proliferation of various cancer cells, and induces G2/M phase arrest and apoptosis. This finding provides a new candidate molecule for anti-cancer drug development based on topo I inhibition.
Keywords: Topoisomerase, Narciclasine (NCS), Topo I-DNA covalent complex, DNA damage, Cell cycle, Apoptosis
Full Article: https://link.springer.com/article/10.1007/s13659-023-00392-1

9. Xylanins A–P, sixteen new guaiane-type dimers from the branches and leaves of Xylopia vielanawith anti-proliferative activity against PANC-1 cell line
Highlight: Sixteen novel guaiane-type sesquiterpene dimers (xylanins A–P) and six known analogues were isolated from Xylopia vielana. Their structures were elucidated using spectroscopic methods and X-ray crystallography. Compound 8 showed the most potent cytotoxicity against PANC-1 pancreatic cancer cells (IC50 = 1.06 μM). Mechanistic studies revealed that compound 8 induces apoptosis, causes S-phase cell cycle arrest, inhibits cell invasion, and promotes autophagy in PANC-1 cells.
Keywords: Structural identification, Sesquiterpenes, Xylopia vielana branches and leaves, Anti-proliferative activity
Full Article: https://link.springer.com/article/10.1007/s13659-025-00574-z

10. Functional roles and regulatory mechanisms of paeonol in the treatment of liver disease
Highlight: This review discusses the therapeutic potential of paeonol, a low-toxicity natural compound from Paeonia lactiflora, in treating liver diseases. It summarizes paeonol's regulatory mechanisms in various liver pathologies and highlights key challenges—poor solubility and rapid metabolism—that limit its clinical use. Strategies such as metabolic regulation and nanocarrier design are proposed to improve bioavailability and liver targeting.
Keywords: Paeonol, Liver diseases, Anti-inflammatory, Signaling pathways, Drug delivery systems
Full Article: https://link.springer.com/article/10.1007/s13659-025-00554-3

11. Advancement in nanocarrier-mediated delivery of herbal bioactives: from bench to beside
Highlight: This review highlights nanocarrier-based systems (nanoparticles, liposomes, nanoemulsions) that enhance stability, bioavailability, and targeted delivery of herbal bioactives like curcumin and resveratrol, overcoming poor absorption and toxicity. These technologies improve therapeutic efficacy in cancer, wound healing, and infection, as demonstrated in preclinical models.
Keywords: Nano-delivery systems, Herbal compounds, Wound healing, Tissue engineering, Bioavailability
Full Article: https://link.springer.com/article/10.1007/s13659-025-00550-7

12. Chalasoergodimers A–E, heterodimers with multiple polymerization modes from a marine-derived Chaetomiumsp. fungus
Highlight: Five new heterodimers (chalasoergodimers A–E) were isolated from marine Chaetomium sp., featuring novel dimerization modes. Chaetoglobosin monomers (9–12) showed cytotoxic activity against A549 lung cancer cells, with compound 12 being the most potent (IC50 = 5.14 μM).
Keywords: Marine-derived fungus, Chaetomium sp., Chaetoglobosin, Cytotoxic activity
Full Article: https://link.springer.com/article/10.1007/s13659-025-00544-5

13. Stingless bee propolis: a comprehensive review of chemical constituents and health efficacy
Highlight: Propolis is rich in bioactive compounds with antioxidant, anti-inflammatory, and anticancer properties. It shows therapeutic potential against various diseases and promotes wound healing. This review compares different propolis types based on their phytochemical profiles and biological effects from preclinical studies.
Keywords: Antioxidant, Nutritional supplements, Chemical analysis, Bioactive constituents, Propolis, Stingless bee
Full Article: https://link.springer.com/article/10.1007/s13659-025-00545-4

14. Vibralactone derivatives isolated from co cultures of the basidiomycetes Stereum hirsutum and Boreostereum vibrans
Highlight: Employing a co-cultivation strategy of the two congeneric fungi, Stereum hirsutum and Boreostereum vibrans, this research led to the isolation of eleven new vibralactone derivatives. Hirsutavibrins A (1) and B (2) showed weak cytotoxicity against the human lung cancer cell line A549, opens a new avenue for fungal co-culturing study between congeneric fungi.
Keywords: Stereum hirsutum, Boreostereum vibrans, Basidiomycetes, Co-culture, Vibralactone
Full Article: https://link.springer.com/article/10.1007/s13659-025-00505-y

15. Asprecosides A-J, ten new pentacyclic triterpenoid glycosides with cytotoxic activity from the roots of Ilex asprella
Highlight: This study reports the isolation and identification of ten new pentacyclic triterpenoid glycosides from the roots of Ilex asprella, including rare 19,22-epoxy ursane and 28,19-lactone ursane types. Compounds such as 7 exhibited moderate cytotoxic activities against H1975 and HCC827 lung cancer cell lines, providing new lead compounds for future structural optimization.
Keywords: Ilex asprella, Pentacyclic triterpenoid glycoside, Ursane, Oleanane, Cytotoxic activity
Full Article: https://link.springer.com/article/10.1007/s13659-025-00499-7

16. Silvaticusins A-D: ent-kaurane diterpenoids and a cyclobutane-containing ent-kaurane dimer fromIsodon silvaticus
Highlight: Three new ent-kaurane diterpenoids and a novel dimer were isolated from Isodon silvaticus. Compounds 2 and 3 were found to exhibit remarkable, broad-spectrum cytotoxic effects against five human tumor cell lines (HL-60, A-549, SMMC-7721, MDA-MB-231, and SW-480).
Keywords: Isodon silvaticus, ent-Kaurane diterpenoid, ent-Kaurane dimer, Cyclobutane moiety, Cytotoxicity
Full Article: https://link.springer.com/article/10.1007/s13659-024-00465-9

17. Current advances on the therapeutic potential of scutellarin: an updated review
Highlight: This updated review systematically summarizes recent research progress on the flavonoid Scutellarin. Beyond its traditional use in cerebrovascular diseases, Scutellarin has demonstrated good therapeutic potential in anti-tumor activities (involving glioma, breast cancer, lung cancer, renal cancer, colon cancer, etc.), anti-inflammation, and anti-oxidation**, positioning it as a versatile natural product with great R&D prospects.
Keywords: Scutellarin, Pharmacological action, Experimental study, Model, Mechanism
Full Article: https://link.springer.com/article/10.1007/s13659-024-00441-3

18. Three previously undescribed metabolites from Cordyceps cicadaeJXCH-1, an entomopathogenic fungus
Highlight: Three previously undescribed compounds with unique structures were discovered from the entomopathogenic fungus Cordyceps cicadae. Notably, compound 2 is a polycyclic polyketide featuring an unusual enol ether moiety and a spiro ring. These compounds were screened for their inhibition against the proliferation of A549 lung cancer cells.
Keywords: Insect pathogenic fungus, Cordyceps cicadae, Steroid, Polyketide, Cyclic dipeptide
Full Article: https://link.springer.com/article/10.1007/s13659-023-00410-2
Follow the Topic
-
Natural Products and Bioprospecting
This is a single blind peer-reviewed open access journal that devoted to rapidly disseminate research results in all areas of natural products.
Your space to connect: The Cancer in understudied populations Hub
A new Communities’ space to connect, collaborate, and explore research on Cancers, Race and Ethnicity Studies and Mortality and Longevity!
Continue reading announcement
Please sign in or register for FREE
If you are a registered user on Research Communities by Springer Nature, please sign in